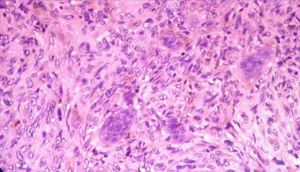
低磷酸鹽血症

簡介
低磷酸鹽血症
低磷酸鹽血症 病因
 低磷酸鹽血症
低磷酸鹽血症 臨床表現
低磷酸鹽血症的症狀為:①中樞神經系統症狀,如感覺異常、構音障礙、反射亢進、震顫、共濟失調、昏迷。
②由於紅細胞 2,3-二磷酸甘油酸減低,紅細胞壽命縮短,可表現球形紅細胞症、溶血。
③乏力,肌肉軟弱,肌肉疼痛,甚至癱瘓。④骨痛(由於骨軟化病), X射線片上可見假骨折。
⑤白細胞吞噬功能障礙,易發生感染。⑥血小板功能障礙,血小板聚集能力降低。
檢查
骨X線檢查:線的影像本身就是對組織吸收X線的直觀反映,而相同照射條件下組織吸收X線的多少取決於組織的密度和厚度。所以當有了骨骼吸收X線的對比標準,就可以依照X線骨密度儀的檢查結果對比得出被檢查人的實際骨密度了。尿液檢查:尿磷增多,尿中鈣與鎂正常或稍低,尿cAMP正常。
血生化檢查:血磷低,常為0.32~0.78mmol/L(1~2.4mg/dl)。血鈣與鎂正常或稍低,血鈣、磷乘積在30以下。血鹼性磷酸酶在活動期升高。血甲狀旁腺激素(PTH)正常或稍高,血1,25(OH)2D3水平亦多正常,但也有減低者。
疾病診斷
最常引起低磷酸鹽血症的原因是鹼中毒(呼吸性及代謝性)。通常低磷酸鹽血症可按下列程式進行鑑別﹕先排除鹼中毒原因後﹐測定尿磷酸鹽。若尿磷酸鹽排泄增加﹐測定血漿鈣。血漿鈣增加﹐則考慮原發性甲狀旁腺功能亢進﹑異位甲狀旁腺﹐惡性腫瘤﹔若血漿鈣正常或減低﹐則考慮繼發性甲狀旁腺功能亢進﹑佝僂病或骨軟化症﹑范可尼氏綜合症﹑低磷酸鹽血性軟骨病。尿磷酸鹽排泄減少﹐應考慮飲食中磷酸鹽攝入減少﹑抗酸藥物治療﹑胰島素治療等。
治療
低磷酸鹽血症可行靜脈內補液及補磷酸鹽糾正。常用的磷酸鹽有磷酸二氫鉀(KH2PO4)及磷酸氫二鈉(Na2HPO4)的混合劑。若同時合併高鈣血症﹐為防移位性鈣化形成﹐靜脈補給磷酸鹽應減少。此外﹐靜脈補給磷酸鹽可引起下列併發症﹕低鈣血症。移位性鈣化形成。醫源性高鉀血症及高鈉血症(補入磷酸鹽引起)。同時應該針對引起低磷酸鹽血症的原因進行治療。
預防
對於禁食,糖尿病酸中毒,甲狀腺功能亢進等易引起低磷血症的患者進行適當的補充磷酸鈣避免其發生。在日常生活中,進行適當的體育鍛鍊,增強體質。

